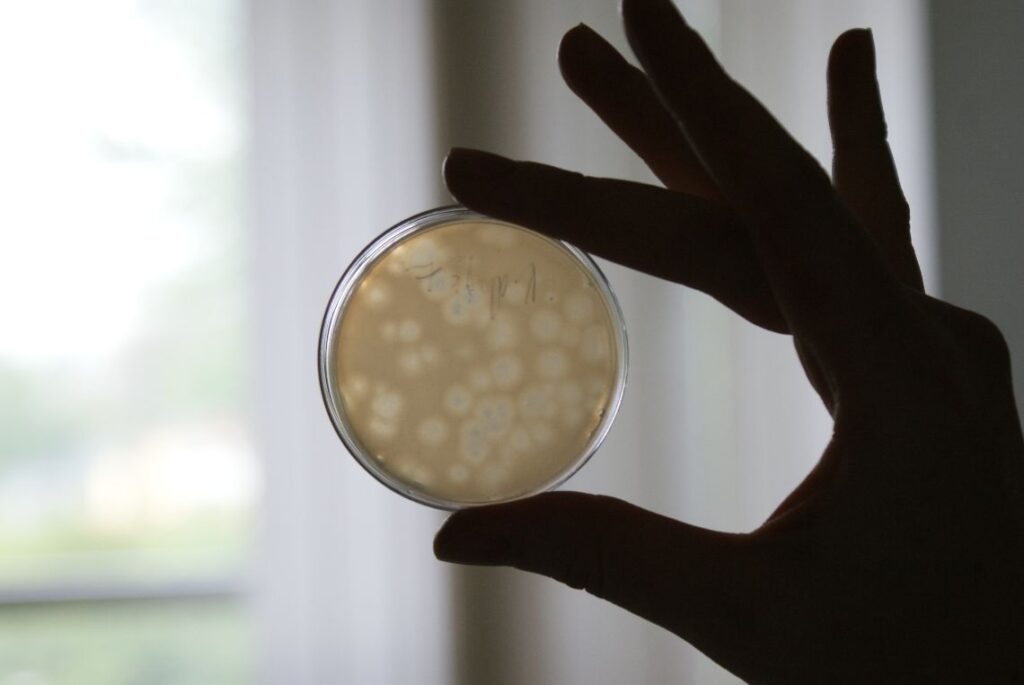

Proteon Pharmaceuticals S.A. została uhonorowana złotym medalem na Międzynarodowych Targach Wynalazczości, Badań Naukowych i Nowych Technologii Brussels Innova 2016 za patent pt. „Sposób otrzymywania szczepu bakteriofaga, specyficzne szczepy bakteriofagowe oraz ich zastosowanie”
Proteon Pharmaceuticals S.A., z siedzibą w Łodzi, z sukcesem rozwija działalność badawczo-rozwojową skoncentrowaną na opracowywaniu preparatów przeciwbakteryjnych nowej generacji, wykorzystujących działanie bakteriofagów w medycynie weterynaryjnej.
Dotychczas firma Proteon opracowała dwa produkty przeznaczone do zwalczania chorobotwórczych bakterii: BAFASAL® i BAFADOR®. BAFASAL® jest dodatkiem paszowym, który zapobiega rozprzestrzenianiu się bakterii Salmonella wśród drobiu hodowlanego. Preparat wypełnia istotną lukę związana z wprowadzeniem w UE w 2006 r. zakazu stosowania antybiotyków jako dodatków paszowych. W 2015 r. preparat został zarejestrowany na Ukrainie. Obecnie trwają zaawansowane prace zmierzające do zarejestrowania preparatu w Europejskim Urzędzie ds. Bezpieczeństwa Żywności. Preparat BAFASAL® jest chroniony patentem w Polsce, Rosji, USA i na Ukrainie.
Drugi preparat – BAFADOR® – jest przeznaczony do zwalczania patogennych bakterii u ryb hodowlanych. W 2016 r. Spółka dokonała zgłoszenia wynalazku w polskim Urzędzie Patentowym. Po pozytywnym zakończeniu procesu rejestracji, firma planuje wprowadzenie produktu na rynki światowe w 2017 r.
Najważniejsze zalety preparatów opracowanych przez firmę Proteon to m.in. działanie przeciwko wybranym gatunkom bakterii chorobotwórczych, natychmiastowe działanie przeciwbakteryjne, brak efektów ubocznych dla ludzi, zwierząt i środowiska oraz całkowita biodegradowalność.
www.proteonpharma.com
Tagi: "Brussels Innova 2016", BAFADOR®, BAFASAL®, bakteriofagi, Proteon Pharmaceuticals S.A., szczepy bakteriofagowe
Dodaj komentarz